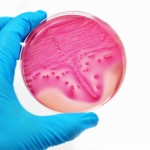

South African epidemiologist Salim Abdool Karim and his wife Quarraisha Abdool Karim will receive the inaugural Olusegun Obasanjo Prize from the African Academy of Sciences for proving the effectiveness of a vaginal gel that can cut a woman’s risk of HIV infection by more than 50 percent. The award’s ceremony will be held in Nairobi, Kenya, according to an article in the Science Insider. The prize is named for the former president of Nigeria, and the $5,000 cash award is a science prize by and for Africans.
To read Science Insider article, click here.
Advertisement
Advertisement
Advertisement

1 Comment
1 Comment